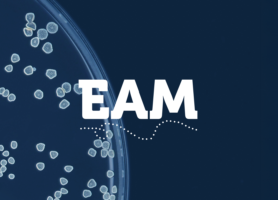

19-03-2026
European Academy of Microbiology welcomes 95 new FellowsNews from the European Academy of Microbiology
15-12-2025
European Academy of Microbiology Announces Professor Cecília M. Arraiano as New PresidentThe European Academy of Microbiology (EAM) is proud to announce the[...]
15-04-2025
#FEMSmicroBlog: Science goes media with the planet of virusesTo better understand the natural course of pandemics, old medical[...]
01-04-2025
Academic institutions worldwide must welcome de-funded US researchersThe European Academy of Microbiology (EAM) finds current actions[...]
19-03-2025
EAM Sessions at FEMS MICRO Milan 2025The European Academy of Microbiology (EAM) is proud to present four[...]
19-03-2025
The future of microbiology is now: Join us at FEMS MICRO Milan 2025Microbiology is not just shaping the future—it[...]
18-02-2025
Leadership Changes at the European Academy of MicrobiologyFrom January 2025, the European Academy of Microbiology has a new[...]
15-10-2024
Prof. Carmen Buchrieser Honoured as the FEMS-Lwoff Awardee 2025The Federation of European Microbiological Societies (FEMS) is proud[...]
24-09-2024
Announcing FEMS MICRO 2025: Magnifying microbial impact in MilanThe global microbiology community is gearing up for the much[...]
17-04-2024
The EAM Meeting 2024: Forging A Future For European MicrobiologyThe European Academy of Microbiology (EAM) held a meeting of its[...]
25-01-2024
microLife Webinar on Nucleotide Second Messenger Signaling in BacteriaFeaturing four authors from our Open Access journal
09-05-2023
EAM fellows running Microbiology 2023 conferenceSeveral EAM fellows including our current president Jörg Vogel, are[...]
14-03-2023
Symposium to honour the legacy of EAM member Pepe CasadesusA symposium was held to honor the memory of our late academy member[...]
14-03-2023
Meet the Winners of the 2022 Best Article Award From microLifeOur academy journal microLife has announced the winners of[...]
24-01-2023
Learn more about the European Academy of MicrobiologyThe European Academy of Microbiology (EAM) is a leadership group of[...]
25-12-2022
Happy Holidays from the EAMHappy holidays and best wishes from the European Academy of[...]
12-12-2022
microLife article feature: Ushering in a new era of single-cell transcriptomics in bacteriaIn this article Christina Homberger, Lars Barquist and Jörg Vogel[...]
05-12-2022
FEMS-Lwoff Award For Achievements In Microbiology 2023 awarded to Professor Kenneth TimmisThe 2023 FEMS-Lwoff Award for Achievements in Microbiology has been[...]
14-11-2022
EAM fellow Jörg Hacker awarded the Robert Koch Gold MedalIt is with great pleasure to announce that EAM fellow Jörg Hacker[...]
19-10-2022
In memoriam César Nombela (1946-2022)It is with great sadness that we learnt that Prof. César Nombela[...]
26-09-2022
Thank you to former microLife Editors-in-Chief Paula Traktman and Matthias HornWe’d like to express our gratitude to Paula Traktman and Matthias[...]
21-09-2022
From Members to Fellows: The European Academy of Microbiology is changingThe title of those elected to the European Academy of Microbiology[...]
05-08-2022
In memoriam Josep CasadesúsAn invitation to hear the last word: Josep (Pep(e)) Casadesús,[...]
19-04-2022
Announcing the new EAM Executive BoardWe are glad to inform you about the results of the EAM Executive[...]
01-03-2022
Recognition from American Society of MicrobiologyThe American Academy of Microbiology (AAM) recently admitted a new[...]
15-02-2022
FEMS Journals hand Article Awards to two EAM membersThe FEMS Journals have announced the winners of their 2021 Article[...]
31-01-2022
We welcome 9 newly elected members to our Academy!The European Academy of Microbiology (EAM) is delighted to welcome 9[...]
12-01-2022
Executive Officer (European Academy of Microbiology)The European Academy of Microbiology (EAM) is seeking an Executive[...]
07-12-2021
We present you with the EAM Members Book!The European Academy of Microbiology (EAM) membership is growing[...]
06-12-2021
Big welcome to our new microLife Section Editors!We are excited to welcome new Section Editors for the journal
03-11-2021
Out Now: Thematic Issue on Extracellular VesiclesWe are proud to announce the publication of the first Thematic Issue[...]
05-07-2021
In memoriam Hans-Dieter Klenk (1938-2021)Hans-Dieter Klenk was an internationally renowned expert in virus research.[...]
28-06-2021
New microLife Thematic Issue: Emerging role of chromatin remodeling in the persistence and elimination of microbial pathogensThere is a new thematic issue for
25-03-2021
EAM president and members support European Foundation for the Prevention of Environmental and Health Crises initiativeIn the midst of the COVID-19 pandemic,[...]
01-03-2021
The EAM is Hosting Two Sessions at the World Microbe ForumThe EAM is hosting two sessions at the
24-11-2020
Professor Jörg Vogel is the New President of the European Academy of MicrobiologyProfessor Jörg Vogel (Würzburg, Germany) has been announced as the[...]
12-10-2020
2020 Nobel Prize in Chemistry Awarded to EAM Member Emmanuelle Charpentier, and Jennifer DoudnaThe 2020 Nobel Prize in Chemistry has been awarded jointly to
27-05-2020
Meet Prof. Matthias Horn, Co-Editor-in-Chief of microLife (1 of 4)We are pleased to announce that there will be four new[...]
27-03-2020
Position paper on Novel Human Pathogenic Coronavirus SARS-CoV-2Eminent virologists Luis Enjuanes, Isabel Sola and Sonia Zúñiga at[...]
16-03-2020
EAM: a complex solution to the AMR crisis is possibleThis interview with worldwide experts on antibiotic resistance[...]
09-01-2020
In memoriam Milton S da Costa (1948-2020)It is with much regret that we share the sad news that former FEMS President[...]
13-10-2019
Pascale Cossart, Professor at the Institut Pasteur (Paris) and FEMS-Lwoff Awardee for 2019During FEMS2019, we managed to talk to Pascale Cossart, Professor at the[...]
09-09-2019
Prof. Hilary Lappin-Scott and Dr. Sara Burton InterviewAt FEMS2019 (7-11 July 2019) in Glasgow, Scotland, we interviewed a range of[...]
29-07-2019
The urgent need for microbiology literacy in societyMicrobes and their activities have pervasive, remarkably profound[...]